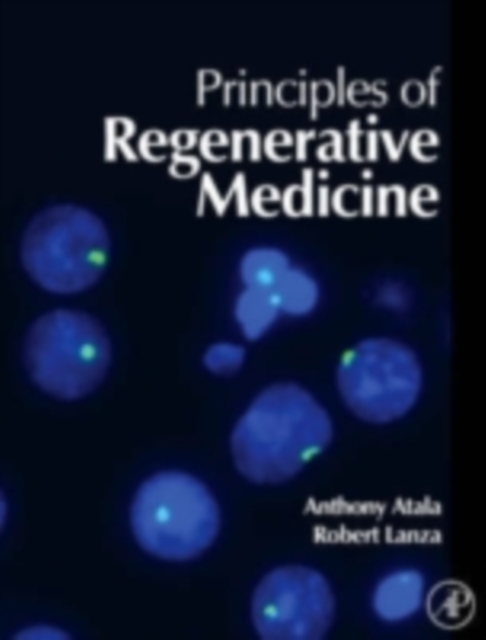
Principles of regenerative medicine

Catalogue Search | MBRL
Search Results Heading
Explore the vast range of titles available.
MBRLSearchResults
-
DisciplineDiscipline
-
Is Peer ReviewedIs Peer Reviewed
-
Item TypeItem Type
-
SubjectSubject
-
YearFrom:-To:
-
More FiltersMore FiltersSourceLanguage
Done
Filters
Reset
8
result(s) for
"Lanza, R. P. (Robert Paul)"
Sort by:
Principles of tissue engineering
by
Lanza, R. P. (Robert Paul)
,
Langer, Robert S.
,
Vacanti, Joseph
in
Animal cell biotechnology
,
Tissue engineering
,
Transplantation of organs, tissues, etc
2020
Now in its fifth edition, Principles of Tissue Engineering has been the definite resource in the field of tissue engineering for more than a decade.The fifth edition provides an update on this rapidly progressing field, combining the prerequisites for a general understanding of tissue growth and development, the tools and theoretical information.
Principles of tissue engineering
by
Langer, Robert S.
,
Vacanti, Joseph
,
Lanza, R. P. (Robert Paul)
in
Animal cell biotechnology
,
Tissue engineering
,
Transplantation of organs, tissues, etc
2014,2013
Now in its fourth edition, Principles of Tissue Engineering has been the definite resource in the field of tissue engineering for more than a decade. The fourth edition provides an update on this rapidly progressing field, combining the prerequisites for a general understanding of tissue growth and development, the tools and theoretical information needed to design tissues and organs, as well as a presentation by the world's experts of what is currently known about each specific organ system. As in previous editions, this book creates a comprehensive work that strikes a balance among the diversity of subjects that are related to tissue engineering, including biology, chemistry, material science, and engineering, among others, while also emphasizing those research areas that are likely to be of clinical value in the future. This edition includes greatly expanded focus on stem cells, including induced pluripotent stem (iPS) cells, stem cell niches, and blood components from stem cells. This research has already produced applications in disease modeling, toxicity testing, drug development, and clinical therapies. This up-to-date coverage of stem cell biology and other emerging technologies -such as brain-machine interfaces for controlling bionics and neuroprostheses- is complemented by a series of new and updated chapters on recent clinical experience in applying tissue engineering, as well as a new section on the application of tissue-engineering techniques for food production. The result is a comprehensive textbook that will be useful to students and experts alike. Includes new chapters on biomaterial-protein interactions, nanocomposite and three-dimensional scaffolds, skin substitutes, spinal cord, vision enhancement, and heart valvesOffers expanded coverage of adult and embryonic stem cells of the cardiovascular, hematopoietic, musculoskeletal, nervous, and other organ systemsFull-color presentation throughout
Handbook of stem cells
2013,2012
New discoveries in the field of stem cells increasingly dominate the news and scientific literature revealing an avalanche of new knowledge and research tools that are producing therapies for cancer, heart disease, diabetes, and a wide variety of other diseases that afflict humanity.
XENO : the promise of transplanting animal organs into humans
by
Cooper, D. K. C. (David K. C.)
,
Lanza, R. P. (Robert Paul)
in
Bio-ethics
,
Bioethics and Medical Ethics
,
MEDICAL
2000
The majority of patients in need of organ transplants do not survive long enough for a suitable human organ to become available. Xenotransplantation, the transplant of animal organs into humans, has attracted substantial media attention. If, as appears likely, it proves possible to “humanize” animal organs and evade the problems of rejection, in the coming few years there will be a tremendous increase in this procedure, mostly using organs from animals specifically for their harvestable organs. This book will lay out the potential and promise of the technique, the history of organ transplantation, the technical problems and breakthroughs in overcoming immune rejection, and typing and humanizing donor organs for transplantation. The ethical question of growing animals specifically for organ harvest, and the substantial public health concern from the certainty that animal viruses will pass into humans with the donated organs, will be fully discussed. The authors are among the leaders in the field of Xenotransplantation.
Principles of regenerative medicine
by
Thomson, James A.
,
Lanza, R. P. (Robert Paul)
,
Atala, Anthony
in
Regeneration (Biology)
,
Regenerative Medicine
2008,2007,2011
Virtually any disease that results from malfunctioning, damaged, or failing tissues may be potentially cured through regenerative medicine therapies, by either regenerating the damaged tissues in vivo, or by growing the tissues and organs in vitro and implanting them into the patient. Principles of Regenerative Medicine discusses the latest advances in technology and medicine for replacing tissues and organs damaged by disease and of developing therapies for previously untreatable conditions, such as diabetes, heart disease, liver disease, and renal failure. * Key for all researchers and instituions in Stem Cell Biology, Bioengineering, and Developmental Biology* The first of its kind to offer an advanced understanding of the latest technologies in regenerative medicine* New discoveries from leading researchers on restoration of diseased tissues and organs
Abundance and Isotopic Composition of Gases in the Martian Atmosphere from the Curiosity Rover
by
Trainer, Melissa
,
Atreya, Sushil K.
,
Manning, Heidi
in
Atmospheric composition
,
Atmospheric sciences
,
Atmospherics
2013
Volume mixing and isotope ratios secured with repeated atmospheric measurements taken with the Sample Analysis at Mars instrument suite on the Curiosity rover are: carbon dioxide (CO 2 ), 0.960(±0.007); argon-40 ( 40 Ar), 0.0193(±0.0001); nitrogen (N 2 ), 0.0189(±0.0003); oxygen, 1.45(±0.09) × 10 -3 ; carbon monoxide, < 1.0 × 10 -3 ; and 40 Ar/ 36 Ar, 1.9(±0.3) × 10 3 . The 40 Ar/N 2 ratio is 1.7 times greater and the 40 Ar/ 36 Ar ratio 1.6 times lower than values reported by the Viking Lander mass spectrometer in 1976, whereas other values are generally consistent with Viking and remote sensing observations. The 40 Ar/ 36 Ar ratio is consistent with martian meteoritic values, which provides additional strong support for a martian origin of these rocks. The isotopic signature δ 13 C from CO 2 of ∼45 per mil is independently measured with two instruments. This heavy isotope enrichment in carbon supports the hypothesis of substantial atmospheric loss.
Journal Article
Factors Associated with the Risk of Adenoma Recurrence in Distal and Proximal Colon
by
Schoen, Robert E.
,
Doubeni, Chyke
,
Pinsky, Paul F.
in
Adenoma - epidemiology
,
Adenoma - pathology
,
Aged
2013
Background/Aims: Colonoscopy may be less effective in preventing cancer in the proximal colon. We evaluated whether risk factors for adenoma recurrence exhibit differential effect on adenoma recurrence by colon subsite. Methods: We examined the association of age, sex, body mass index, smoking status and use of nonsteroidal anti-inflammatory drugs (NSAIDs) on proximal and distal adenoma recurrence among 1,864 participants in the Polyp Prevention Trial. We used multinomial logistic regression models to calculate the relative risk ratios (RRR) and 95% CI. Results: 733 (39.3%) participants had adenoma recurrence (228 distal only, 369 proximal only and 136 synchronous proximal and distal adenoma). When compared to participants without adenoma recurrence, no factor was associated with an increased risk of distal only adenoma recurrence. Age 65-69 years (RRR = 1.47, 95% CI 1.00-2.16), age ≥70 years (RRR = 2.24, 95% CI 1.57-3.20), and male sex (RRR = 1.73, 95% CI 1.32-2.27) were positively associated with proximal only adenoma recurrence. NSAIDs use was associated with a reduced risk of adenoma recurrence by similar magnitude in distal (RRR = 0.78, 95% CI 0.58-1.07) and proximal colon (RRR = 0.77, 95% CI 0.60-1.00). Conclusions: We did not find any modifiable risk factor that differentially increases proximal as compared to distal adenoma recurrence to be clinically useful for targeted intervention.
Journal Article